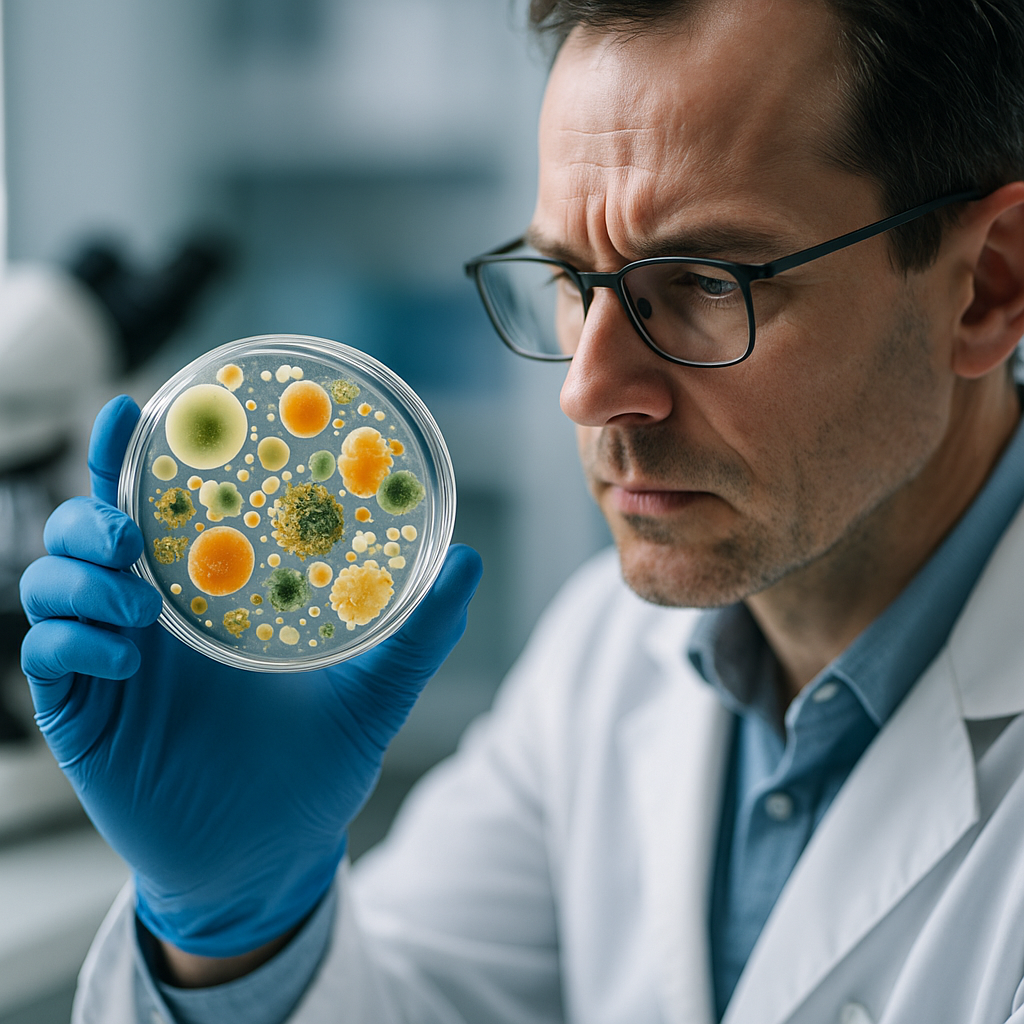
Gut Bacteria Transplants Reverse Autism Symptoms 80%

Trends Today - Latest Articles - Page 5
Page 5 of 10 • 120 total articles
Latest Articles - Page 5

Revolutionary Space Debris Solutions How New Technologies Are Cleaning Earth Orbit
David Kim•9/19/2025

How Scientists Just Decoded the Secret Language of Memory Formation in Real Time
Sarah Martinez•9/19/2025